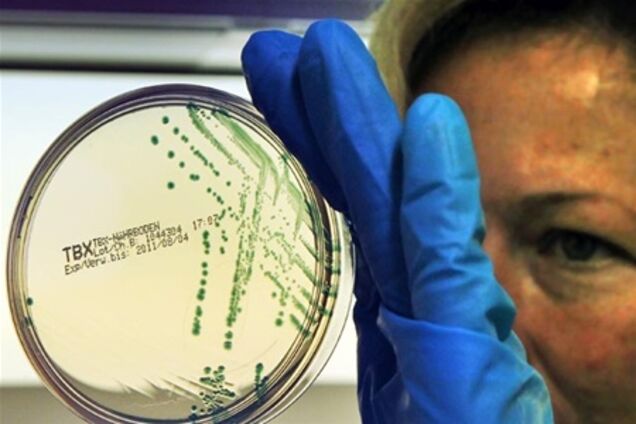
В Европе найден новый источник кишечной палочки-убийцы

В Европе найден новый источник кишечной палочки-убийцы
Виртуальный мемориал погибших борцов за украинскую независимость: почтите Героев минутой вашего внимания!
Загадочная кишечная инфекция, поразившая Европу в конце мая и погубившая, по данным Reuters, уже 30 человек, продолжает распространяться и убивать. Первый случай заражения зафиксирован в Словакии, а в Германии за минувшие сутки скончались трое заболевших.
Между тем бактерию Esherichia coli (E.coli) находят в овощах, которые ранее не вызывали подозрений: так, в Таиланде оказались заражены импортированные из Европы авокадо. Одновременно в Нидерландах обнаружили бактерии еще одной новой разновидности E.coli - они найдены в свекольной ботве.
В Германии источник заражения ищут на фермах, в супермаркетах, в мусорных баках, в ресторанах. Больницы на севере страны едва справляются с потоком заболевших. Тяжелобольные нуждаются в донорской крови и плазме.
"Нужно очень много крови и ее компонентов, в Шлезвиг-Гольштейне и в Гамбурге плазмы не осталось. Последние дни мы организуем кампании по сбору крови, люди проявляют сочувствие, число доноров постепенно растет", - рассказал Йенс Лихте, представитель Красного Креста в Гамбурге.
Новый "подозреваемый"
В настоящее время немецкие власти, продолжая поиски источника инфекции, взяли под подозрение компанию общественного питания, которая занималась выездным ресторанным обслуживанием дня рождения в одном из населенных пунктов недалеко от Геттингена 28 мая, сообщили агентству Reuters представители местных властей.
Восемь гостей, побывавших на этом мероприятии, заболели. При этом у одного из них подтверждено наличие бактерии Esherichia coli, а у двух остальных выявлен гемолитикоуремический синдром. Это состояние, при котором у пациента наблюдается внезапное быстрое разрушение эритроцитов, вызванное острой почечной недостаточностью, возникшей в результате частичной или полной непроходимости мелких почечных артерий.
Но проверка пока не завершена. Руководство компании общественного питания активно сотрудничает с властями. Сами они заверяют, что прилагают все усилия к скорейшему разрешению проблемы. В ответ на недовольство, ощущаемое в соседних европейских странах, такое заявление вынуждена была сделать лично канцлер ФРГ Ангела Меркель. Однако другие государства не только критикуют германские власти, но и вынуждены теперь бороться с заражением уже на своей территории.
Кроме ФРГ, случаи болезни отмечены в 10 странах Евросоюза, а также в США. Почти все случаи в ЕС или США так или иначе связаны с визитами граждан этих стран на север Германии, передает РБК.
В Словакии в больницу города Кошице доставлен 25-летний мужчина с острой почечной недостаточностью, вызванной кишечной палочкой, сообщают "Вести". Судя по симптомам, источник заболевания - именно в Германии.
Новые зараженные овощи
В Таиланде палочкой заражена партия авокадо из Испании. Медики ждут окончательных результатов исследований. Вместе с авокадо проверяют и бельгийскую капусту. Правительство азиатского королевства уже обратилось к местным жителям с призывом покупать только местные фрукты и овощи.
По мере того, как растет список подозрительных продуктов, растут и убытки европейских сельхозпроизводителей. Уже ясно, что речь идет о сотнях миллионов евро. Две недели спустя после начала эпидемии очевидно, что болезнь не отступит быстро, и в одиночку странам Европы с ней не справиться.
В Нидерландах найдена новая разновидность E.coli
Между тем лабораторные анализы, проведенные в Нидерландах, выявили новую разновидность бактерии Esherichia coli. Сначала бактерию нашли в свекольной ботве. Власти сразу отозвали свою сельскохозяйственную продукцию из трех стран, а министр сельского хозяйства Хенк Блекер на встрече с фермерами заявил, что им следует тщательнее мыть и обрабатывать свеклу.
Пострадавших в Нидерландах пока мало, погибших не зафиксировано. Фермеры выражают сочувствие своим германским коллегам, которым предстоит понести огромные убытки.
В России продолжает действовать запрет на ввоз овощей из ЕС, установленный Роспотребнадзором в начале июня. Власти стран Европы выразили резкое недовольство этой мерой, но руководитель Роспотребнадзора, Главный государственный санитарный врач РФ Геннадий Онищенко ответил, что запрет не будет снят до полного выяснения причин и обстоятельств распространения инфекции, а также данных о ее возбудителе, между тем пока Москве не сообщили исчерпывающей информации об этом.










